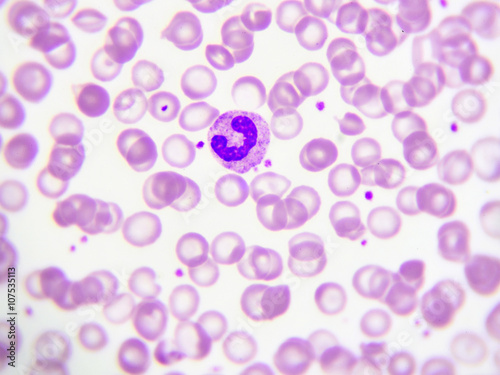
Band form neutrophil cell (white blood cell) in peripheral blood smear, Wright stain

Minimum order: $100.00
Upload a photo of your room and see how this design would look on your walls.
Generate up to 5 room visualizations per day for free.
Click to sign in and get started
Customised and printed to fit your wall dimensions perfectly.
Eco-friendly, PVC-free materials and GREENGUARD Gold certified inks.
Change colors, move elements, or adjust scale at no extra cost.
Fast and free shipping to your doorstep, anywhere in the world.